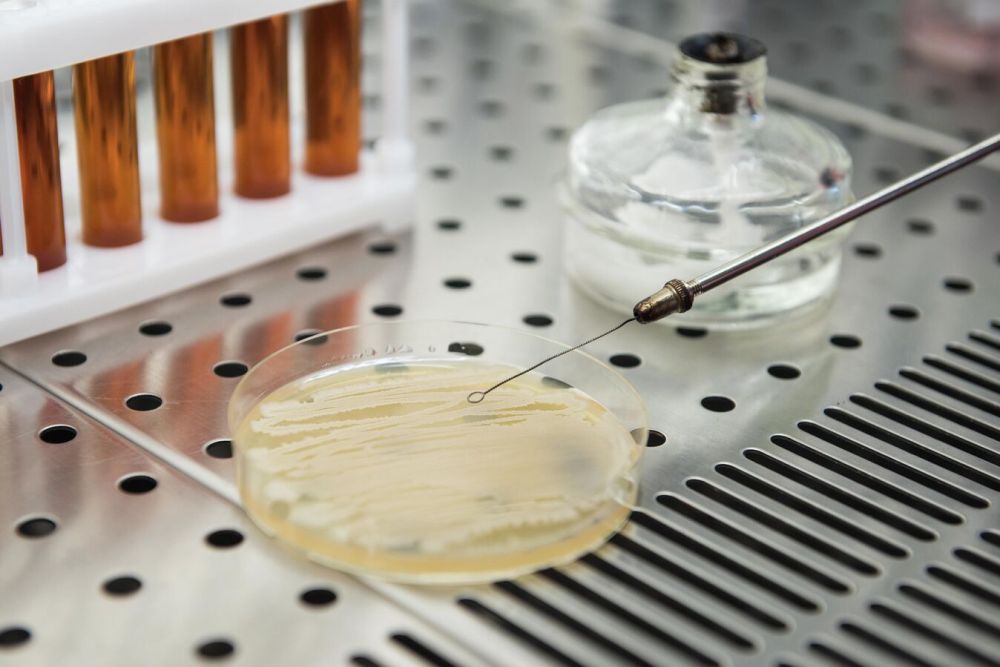
�������� �������� � ������������ � ���� � �������������� ��� ��������

В акватории Черного моря минувшей ночью уничтожено два безэкипажных катера Они следовали в направлении Крымского полуострова. Также над Черным морем силами ПВО было уничтожено пять БПЛА самолетного типа, сообщили в Минобороны РФ. // Главное в Херсоне и области
Новости за 16.08.2024
В течение прошедшей ночи дежурными средствами ПВО перехвачено и уничтожено пять БПЛА самолетного типа над акваторией Черного моря. Кроме того, дежурными огневыми средствами в акватории Черного моря уничтожены два...
Фронтовая сводка по состоянию на утро пятницы, 16 августа:На Покровском направлении фронт у противника сыплется не по дням, а по часам. Противник заявляет, что до самого Покровска нашим бойцам осталось 10-12 км по прямой. Покровск, он же...
Власти США превратили Украину «из государства в военный антироссийский проект», утверждает помощник президента РФ Николай Патрушев. По его словам, Вашингтон создал все предпосылки для потери Украиной части территорий.«Усилиями Вашингтона созданы все...
Доброе утро, друзья!Пусть новый день начинается легко и с прекрасным настроением! Желаем безоблачного дня, достижения поставленных целей и побольше радости в жизни!
Операторы беспилотных летательных аппаратов группировки войск «Днепр» выявляют и уничтожают средства связи ВСУ на правом берегу Днепра
Подразделения БпЛА арктической бригады из состава группировки войск «Днепр» уничтожают...
В течение прошедшей ночи при попытке киевского режима совершить террористическую атаку с применением беспилотных летательных аппаратов по объектам на территории Российской Федерации дежурными средствами ПВО перехвачено и уничтожено пять БПЛА...
Британское МВД рекламирует в TikTok тюремные сроки за участие в протестахВласти выпустили предупреждение с заголовком: «Действия имеют последствия». Перечень «преступлений» показывают британским пользователям TikTok в качестве рекламы.Участникам...
Конец рабочей недели должен порадовать жителей Херсонской области хорошей погодойСогласно прогнозам синоптиков, в течение сегодняшнего дня будет светить солнце, осадков не ожидается, а воздух может прогреться до плюс 32 градусов....
Доброе утро, друзья!Делюсь с вами прекрасными снимками невероятного восхода солнца на Арабатской стрелке. Присылайте фотографии ваших любимых мест в комментарии или в бот обратной...
Председатель ЛДПР назначил вознаграждение за поимку украинских нацистовЛеонид Слуцкий готов заплатить 5 миллионов рублей тем, кто найдет и пленит неонацистов, которые издевались над пенсионером из Курской области и сняли это на видео. Это были солдаты...
#Курская область #Сводка на утро 16 августа 2024 года Боевые действия в регионе характеризуются как манёвренная война: противник рейдовыми действиями старается занимать территорию и населенные пункты, ВС России встречными действиями выбивает...
Ульяновские артиллеристы-десантники уничтожили САУ противника на правом берегу Днепра в Херсонской области
Подразделения гвардейского артиллерийского полка ульяновских десантников из состава группировки войск «Днепр» ежедневно ведут...
МОСКВА, 16 авг – РИА Новости. Эпидемиологическая обстановка по острым кишечным инфекциям в новых регионах России стабильная и контролируемая, вспышки заболевания не зарегистрировано, заявили РИА Новости в Роспотребнадзоре.Ранее в пророссийском...
В одном украинском городе на границе с Курской областью проходит челендж — кто быстрее найдет рефку для перевозки трупов. Рефрижераторов надо много. Так как трупов тоже много.Кроме машин с холодильниками нужна кровь, вода, свет, газ … и далее...
ГЕНИЧЕСК, 16 авг - РИА Новости. В питьевой воде в подконтрольном ВСУ городе Никополе Днепропетровской области Украины обнаружены сальмонеллы, сообщили РИА Новости в пророссийском подполье города Херсон. «"В город Никополь из города...
В питьевой воде в украинском Никополе обнаружены сальмонеллы, сообщили РИА Новости в пророссийском подполье подконтрольного ВСУ Херсона.В город Никополь из города Кропивницкий прибыли специалисты Кировоградского областного центра...
Ночная атака на Крым и Севастополь: помимо подавления БПЛА над Керчью и акваторией, сообщалось об уничтожения надводных БЭКов.По предварительным данным — гражданские объекты не пострадали.ПОДПИСАТЬСЯ#насамомделе...
Подразделение гвардейского артиллерийского полка Ульяновских десантников уничтожило самоходную артиллерийскую установку ВСУ на Херсонском направлении в зоне СВО.Об этом сообщила пресс-служба Минобороны России.«После попадания у вражеской САУ...
Российские операторы БПЛА поразили антенны связи ВСУ на Каховском направлении в зоне проведения СВО.Об этом сообщила пресс-служба Минобороны России.«Несколько антенн и ретрансляторов, используемых противником, были уничтожены», — заявили представители...